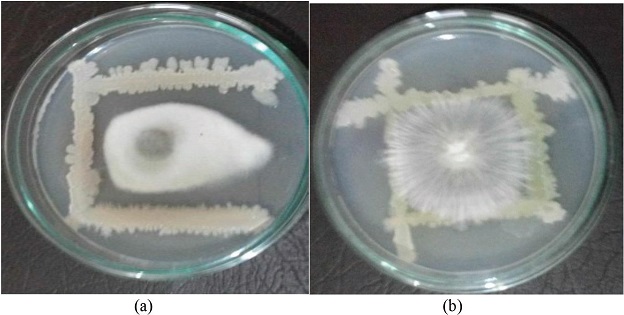
Graphical Abstract

Isolation and characterization of Soybean DREB 3 transcriptional activator
Sarosha Nasreen, J. Amudha, S. S. Pandey
DOI: 10.7324/JABB. 2013.1202Pages: 009-012

Crosstalk of brassinosteroids with other phytohormones under various abiotic stresses
Farhan Ahmad, Ananya Singh, Aisha Kamal
DOI: 10.7324/JABB.2018.60110Pages: 56-62

Role of glutathione reductase and catalase enzyme in antioxidant defense mechanism in controlling fluoride-induced oxidative stress
Komal Sharma, Mamta Choudhary, Khushbu Verma
DOI: 10.7324/JABB.2020.80109Pages: 53-58

Evaluation of Bacillus subtilis MRB4, as plant growth promoter and potential phosphate solubilizer under abiotic stress
Nishat Khatoon, Mazharuddin Khan
DOI: 10.7324/JABB.2020.80504Pages: 27-35
Implications of abiotic stress tolerance in arbuscular mycorrhiza colonized plants: Importance in plant growth and regulation
Madhulika Singh, Sanskriti Bisht, Shatrupa Singh, Jai Gopal Sharma
DOI: 10.7324/JABB.2022.100601Pages: 1-11
